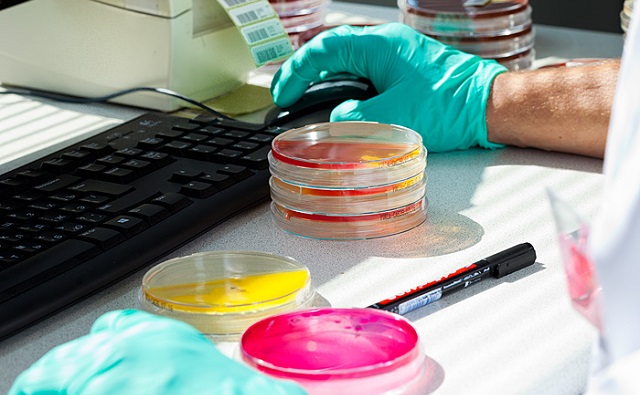
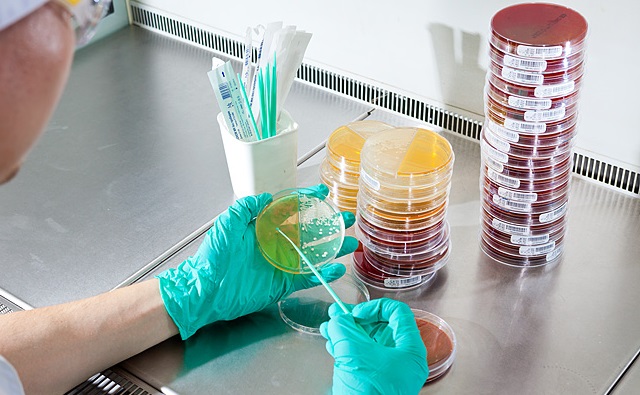

Федеральная сеть медицинских лабораторий «Гемотест» объявила о скидке на покупку франшизы. Новым партнёрам из Ростовской области, которые заключат договор коммерческой концессии до 31 декабря 2019 года, предлагают особые условия сотрудничества: скидку 30% на паушальный взнос и сниженную ставку агентского вознаграждения на первые 12 месяцев работы (50% выручки от лабораторных услуг).
Франшиза «Гемотест» предполагает открытие лабораторного отделения под брендом компании. Партнёры организуют обслуживание пациентов, правильное взятие и хранение биоматериала. А головная компания отвечает за его транспортировку в лабораторию, выполнение исследований на высокоточном автоматизированном оборудовании, проверку результатов врачами и их отправку пациентам.
«Компания выполняет более 2500 видов исследований, использует новейшие метолы лабораторной диагностики, её результатам доверяют все частные и государственные медицинские учреждения России», — рассказали в компании «Гемотест».
Как отмечают в компании, размер инвестиций в открытие медицинского бизнеса по франшизе зависит от численности населения в городе.
Например, в Ростове они составят от 1,85 миллиона рублей, сумма паушального взноса с учётом скидки — 140 тысяч рублей. Открытие точки в городах с населением от 50 до 250 тысяч человек (Волгодонск, Новочеркасск, Батайск, Новошахтинск) потребует 1,5 миллиона рублей. Предприниматели из небольших городов и станиц могут вложить около 750 тысяч. Размер роялти во всех случаях одинаков и составляет 0,18% дохода от услуг лабораторной диагностики.
«Доходность лабораторных отделений достигает 46%. Независимо от типа населённого пункта и региона, в котором открыта точка, франчайзи компании выходят на точку безубыточности к 3-му месяцу работы и окупают вложения в течение полутора лет», — подчеркнули в компании.
Кроме того, при покупке франшизы «Гемотест» новым партнёрам гарантируют бесплатное обучение основам ведения бизнеса, финансового учёта, кадрового делопроизводства и медицинским стандартам в собственной школе и подготовку персонала лабораторного отделения в тренинговом центре и при помощи вебинаров.
За каждым франчайзи с первого дня работы закрепляют команду управления, которая помогает развивать бизнес и решать сложные вопросы. Компания бесплатно обеспечивает партнёра качественными расходными материалами, формирует индивидуальные медиапланы для продвижения на региональном и локальном уровнях, предоставляет маркетинговую поддержку.
В компании добавили, что франшиза «Гемотест» возглавляет рейтинг РБК «Топ-50 самых популярных франшиз в России» в категории «Медицина», а также признана лучшей франшизой медицинских услуг по версии премии «Развитие регионов. Лучшее для России».
Сергей Огурцов
Поделиться:
1,8 м/c
56%
752 мм рт. ст.

